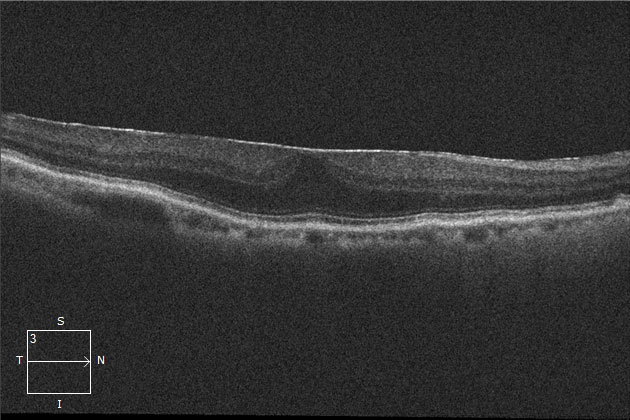
OCT検査画像

目の病気について
網膜前膜
網膜の中心にある黄斑の表面に薄い膜ができる病気です。網膜上膜、黄斑上膜、黄斑前膜、セロファン黄斑症、などとも呼ばれています。
加齢に伴って形成される特発性のものがほとんどですが、他の病気に伴って生じる続発性のものもあります。
初期には自覚症状はなく、検診などで偶然発見されることも珍しくありません。進行すると、網膜にしわができるために、物がゆがんで見え(変視症)、視力低下が生じます。
基本的には進行が非常にゆっくりであることが多く、数年から10数年の経過でじわじわと進行していきます。
種類と原因
「特発性」と「続発性」に分けられます。
特発性網膜前膜
加齢に伴う生理現象である「後部硝子体剥離(こうぶしょうしたいはくり)」が主な原因です。
後部硝子体剥離とは、眼内を満たしている無色透明なゼリー状の硝子体が、加齢とともに徐々に液状に変化し網膜から剥がれる現象を言います。
この時に硝子体組織が網膜からきれいに剝がれず、黄斑部に残り薄い膜となったものが網膜前膜(黄斑前膜)です。
硝子体の変性は通常50~70代で、早ければ40代で始まります。加齢が原因で自然に起こるものなので、有効な予防策はありません。
続発性網膜前膜
外傷、ぶどう膜炎、網膜剥離などを原因として起こる網膜前膜です。
特に年齢に関係なく発症します。
- OCT検査による画像

正常OCT
網膜前膜のOCT
症状
- 視力低下(ゆっくり進行することが多い)
- 物がゆがんで見える
- 物が大きく見える
- 小さい文字が読みづらい
治療
点眼や内服薬で有効なものはありません。自覚症状が軽度の場合には経過観察をします。 自然に網膜から剥がれることもありますが、極めて稀です。病態が進行し、変視症が強くなる、視力が低下するといった症状が自覚されるようになったら、網膜前膜を取り除く硝子体手術を行います。